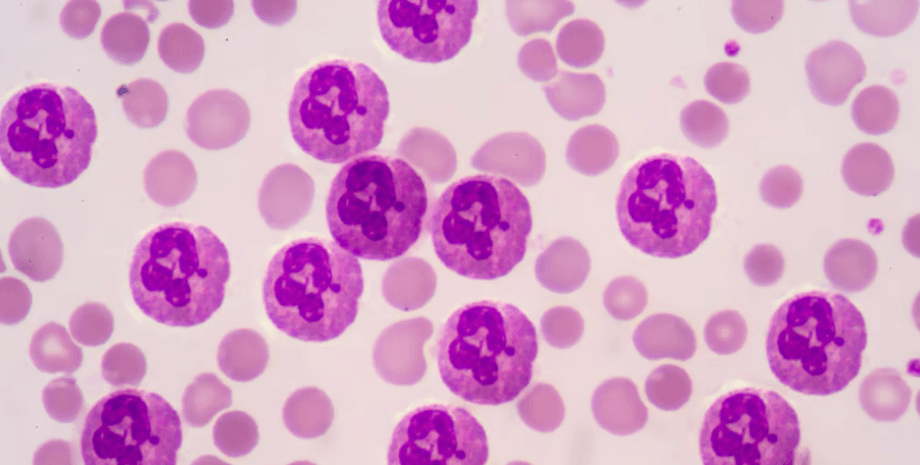
нейтрофилы, клетки крови

Вечная химия. Как повседневное использование предметов быта нас убивает — рассказывают ученые
Согласно новому исследованию, жизненно важные функции иммунных клеток, называемых нейтрофилами, могут быть нарушены токсичными химическими веществами, с которыми мы соприкасаемся каждый день.
Негативное воздействие химических веществ, называемых ПФАВ, на здоровье продолжает оставаться открытым. Ученые из Университета штата Северная Каролина (УСК) показали, что некоторые типы ПФАВ могут нарушать жизненно важные функции иммунных клеток. Эта группа веществ входит в состав водоотталкивающих покрытий на ткани, антипригарных покрытий на посуде и защитной упаковки на продуктах.
Пер- и полифторалкильные вещества (ПФАВ) представляют собой широкую группу химических веществ, которые становятся все более и более проблематичными по мере того, как проводится больше исследований по ним. Поскольку они были разработаны в 1940-х годах, их антипригарные и водоотталкивающие свойства сделали их привлекательными для широкого круга применений в обычных бытовых товарах, пишет New Atlas.
У Фокус. Технологии появился свой Telegram-канал. Подписывайтесь, чтобы не пропускать самые свежие и захватывающие новости из мира науки!
Только позже их влияние на здоровье стало очевидным. Воздействие ПФАВ было связано, среди прочего, с диабетом, низким весом при рождении, проблемами с фертильностью, заболеваниями щитовидной железы и различными видами рака. Хуже того, их долгая жизнь и обилие делают их уязвимыми для окружающих.
В новом исследовании команда УСК исследовала влияние девяти различных молекул ПФАВ на врожденную иммунную систему, которые ранее не были хорошо изучены. Команда протестировала ПФАВ на иммунных клетках, называемых нейтрофилами, одними из первых реагирующих на инфекцию организмов, которые борются, сбрасывая активные формы кислорода на патогены в процессе, называемом респираторным взрывом.
Были протестированы три группы нейтрофилов: некоторые были культивированы из образцов крови человека, некоторые получены из эмбрионов рыбок данио, а некоторые — из других клеток, которые были химически обработаны, чтобы вести себя как нейтрофилы. Каждая группа подверглась воздействию растворов девяти химических веществ ПФАВ, все из которых были обнаружены в реке Кейп-Фир в Северной Каролине, а также крови людей в этом районе.
Один ПФАВ был особенно проблематичным — GenX, более позднее химическое вещество, которое было введено для замены более раннего, более токсичного ПФАВ, но в конечном итоге было обнаружено, что у него есть свои проблемы, связанные с вредом здоровью. В этом случае было обнаружено, что GenX нарушает процесс респираторного взрыва во всех трех группах, потенциально ослабляя иммунный ответ на патогены. Было обнаружено, что второй ПФАВ, называемый PFHxA, также подавляет этот процесс, но только у рыбок данио и нейтрофилоподобных клеток.
Команда говорит, что это исследование раскрывает новые проблемы, связанные с этими и без того проблемными химическими веществами, но необходимо провести дальнейшую работу, чтобы выяснить, как они могут влиять на врожденную иммунную систему на уровнях, которым подвергаются обычные люди.
"Самое продолжительное химическое воздействие в нашем исследовании составляло четыре дня, поэтому, очевидно, мы не можем сравнивать это с реальным воздействием на человека в течение четырех десятилетий", — сказал Джефф Йодер, корреспондент исследования. — Мы наблюдали за высокой дозой одного ПФАВ в течение короткого периода времени, в то время как люди в бассейне реки Кейп-Фир подвергались воздействию смеси ПФАВ низкой дозы в течение длительного периода. Поэтому, хотя мы можем сказать, что наблюдаем токсический эффект от высокой дозы в клеточных линиях, мы пока не можем сказать, какие последствия долгосрочное воздействие может в конечном итоге оказать на иммунную систему".
Ранее Фокус писал о том, что опасность тефлоновых сковородок — доказана учеными. Исследователи обнаружили, что даже крохотное повреждение поверхности способно высвободить миллионы опасных микроскопических частиц.
